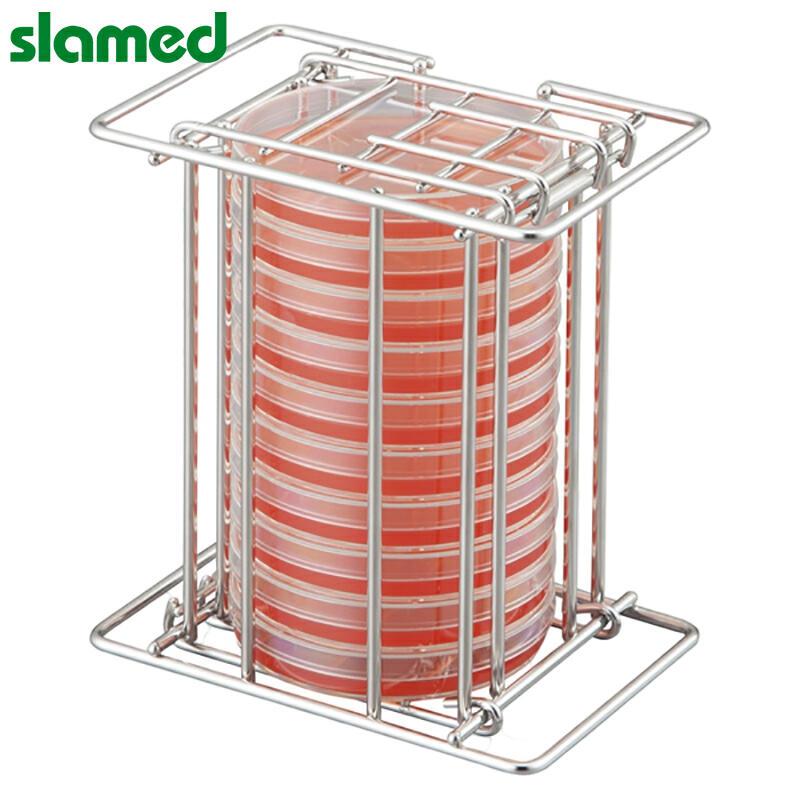

Login
Register
Logout
Member Center
Shopping Cart

Product

Serach
ACCURATE
Big data positioning
MAJOR
All-round marketing service
SHOPPING
Save time and effort,
buy it at one stop